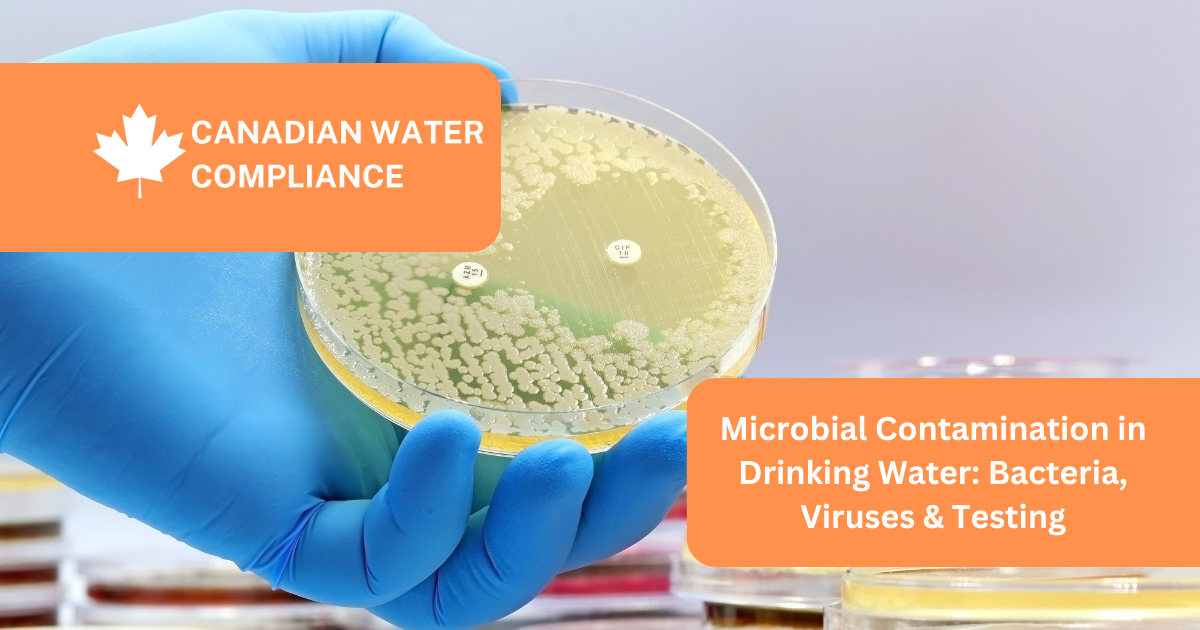
Microbial Contamination in Drinking Water: Bacteria, Viruses & Testing

Microbial Contamination in Drinking Water: What You Need to Know
Learn about microbial contamination in drinking water, including E. coli, Legionella, and Giardia. Discover health risks, testing methods, and treatment solutions.

Stay up to date with the latest news and updates from Canadian Water Compliance on E. coli in Drinking Water.
Learn about microbial contamination in drinking water, including E. coli, Legionella, and Giardia. Discover health risks, testing methods, and treatment solutions.